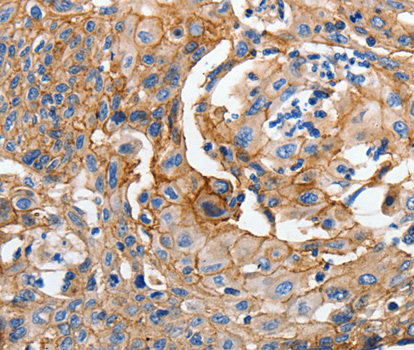
A3044: image 2

For quotations, please use our online quotation form, and you may also contact us by
service@kendallscientific.com
+1-888.733.6849 (Toll-free)
+1-617.299.7367 (Int’l))
+1-888.733.6849
Our customer service representatives are available 24 hours, Monday through Friday to assist you.| Reactivity | Human Mouse Rat |
| Tested applications | WB IHC IP |
| Recommended Dilution | WB 1:500 - 1:2000 IHC 1:50 - 1:200 IP 1:20 - 1:50 |
| Calculated MW | 135kDa |
| Observed MW | Refer to Figures |
| Immunogen | A synthetic peptide of human CDH1 |
| Storage Buffer | Store at -20℃. Avoid freeze / thaw cycles. Buffer: PBS with 0.02% sodium azide, 50% glycerol, pH7.3. |
| Concentration | dt |
| Synonym | CDH1; Arc-1;CD324 ;CDHE ; ECAD;LCAM ; UVO ;E-Cad/CTF3 ;Uvomorulin; E-Cadherin; |

Western blot analysis of extracts of mouse lung, using CDH1 antibody.
Immunohistochemistry of paraffin-embedded human cervical cancer tissue, using CDH1 antibody.

Immunohistochemistry of paraffin-embedded human esophagus using CDH1 antibody at dilution of 1:200 (40x lens).

Immunohistochemistry of paraffin-embedded human gastric using CDH1 antibody at dilution of 1:200 (40x lens).
This gene is a classical cadherin from the cadherin superfamily. The encoded protein is a calcium dependent cell-cell adhesion glycoprotein comprised of five extracellular cadherin repeats, a transmembrane region and a highly conserved cytoplasmic tail. Mutations in this gene are correlated with gastric, breast, colorectal, thyroid and ovarian cancer. Loss of function is thought to contribute to progression in cancer by increasing proliferation, invasion, and/or metastasis. The ectodomain of this protein mediates bacterial adhesion to mammalian cells and the cytoplasmic domain is required for internalization. Identified transcript variants arise from mutation at consensus splice sites. [provided by RefSeq, Jul 2008]
N/A